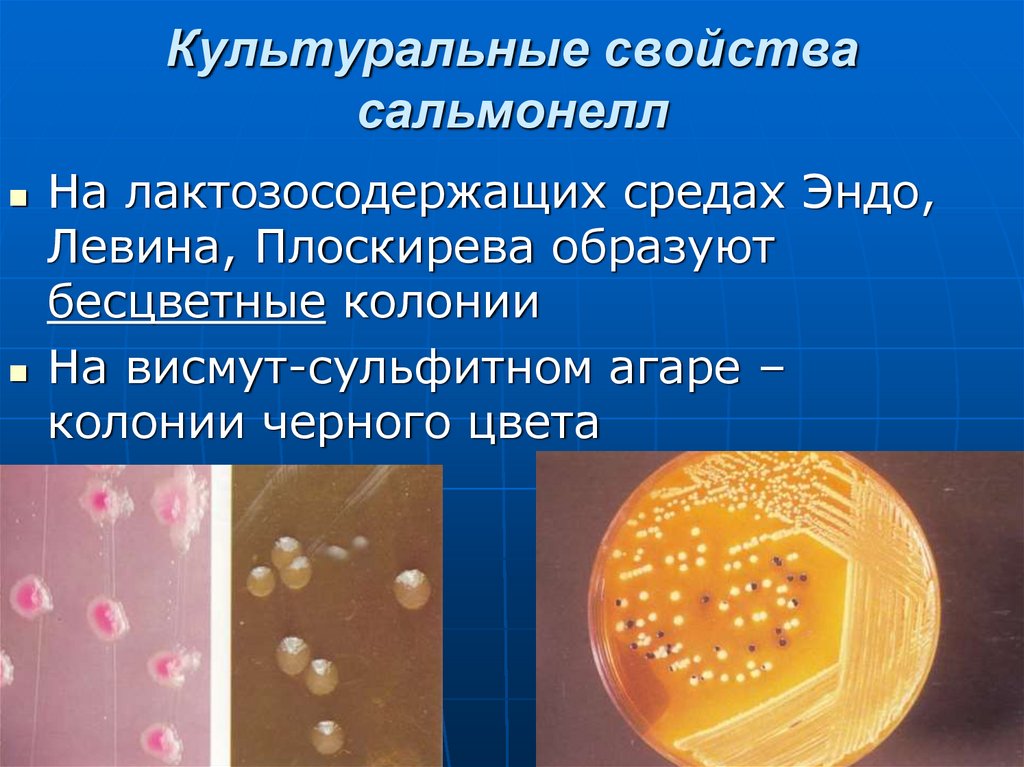
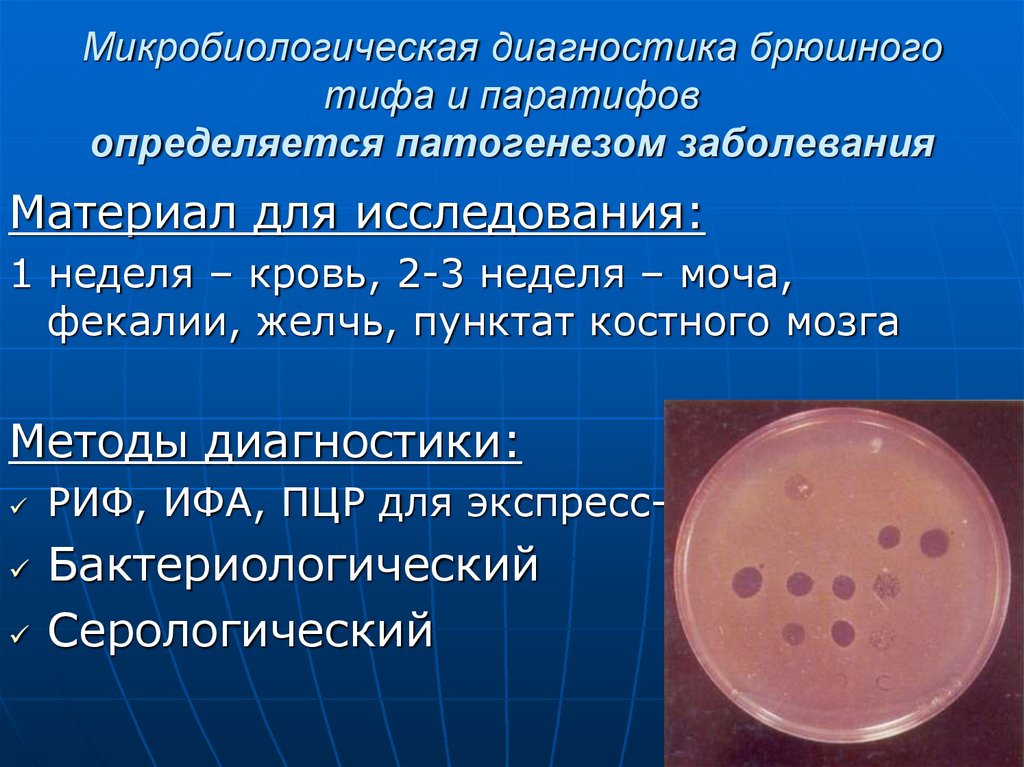
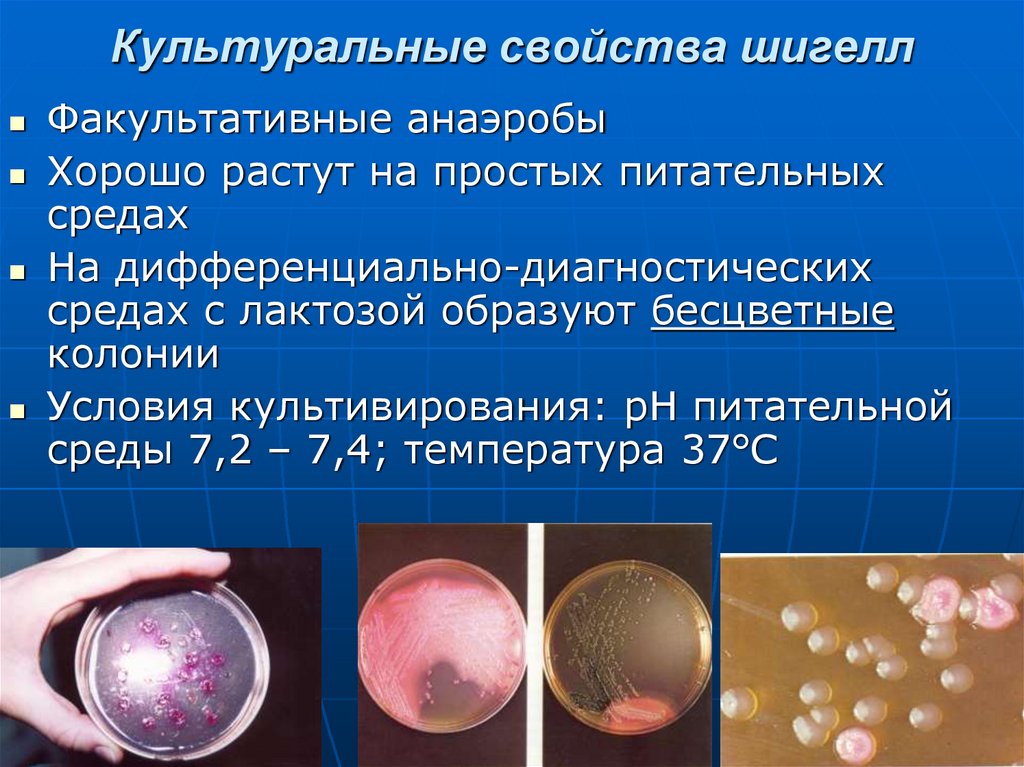

Similar presentations:
Бактерии - возбудители кишечных инфекций
1. Бактерии - возбудители кишечных инфекций
2. Кишечные инфекции – это большая группа заболеваний, которые передаются фекально-орально и характеризуются преимущественным
поражениемразличных отделов ЖКТ.
Этиология: бактерии, вирусы, простейшие
и микроскопические грибы, микробные
токсины
3. Реализация фекально-орального механизма заражения
4. Заболеваемость кишечными инфекциями
Ежегодно в мире болеетоколо 500 млн. человек,
и около 3 млн. человек погибает
В развивающихся странах около
4500 детей до 5 лет ежедневно
умирает от диареи
1,1 млрд. человек не имеют доступа
к безопасной воде и
2,6 млрд. человек – к средствам
санитарии и гигиены
5. Заболеваемость кишечными инфекциями
В России –ежегодно около 1 млн. случаев
6. ТАКСОНОМИЧЕСКОЕ ПОЛОЖЕНИЕ ЭНТЕРОБАКТЕРИЙ
Семейство –Enterobacteriaceae
Род Salmonella
Род Shigella
Род Escherichia
Род Yersinia и др.
7. Кишечные палочки (эшерихии) – Escherichia coli
8. Теодор Эшерих (1857-1911)
Немецкий педиатрВыделил E. coli из
фекалий ребенка,
больного «детской
холерой» (1885)
Назвал Bacterium coli
commune
9. Морфологические и тинкториальные свойства
Мелкие грамотрицательные палочки сзакругленными концами
Спор и капсул не образуют
Могут иметь микрокапсулу
Подвижны (перитрихи)
Имеют пили (фимбрии)
10. Культуральные свойства эшерихий
Факультативные анаэробыХорошо растут на простых
питательных средах
На жидких средах дают диффузное
помутнение
Условия культивирования: рН 7,2 –
7,4; оптимальная температура 37°С
11. Культуральные свойства эшерихий
На лактозо-содержащихдифференциальнодиагностических средах
образуют окрашенные колонии
(за счет утилизации лактозы)
Рис. - среда Эндо и колонии E.coli
12. Биохимические свойства эшерихий
Высокая биохимическая активностьГлюкоза «+»
Лактоза «+»
Индол «+»
Н2S «–»
Утилизация цитрата «–»
13. Антигенные свойства эшерихий
Имеют О-, Н-, К-антигеныО-(170 разновидностей), К- (~100), Н- (~70)
Делят на серогруппы/серовары
Антигенная формула серовара записывается
так - О55:К5:Н26; О157:Н7
Определяют в реакции агглютинации на
стекле
14. Классификация эшерихий
Различаются по антигенным свойствами факторам патогенности
Делят на 2 биовара:
Биовар 1 – условно-патогенные
эшерихии (нормальная микрофлора) –
могут вызывать
п а р е н т е р а л ь н ы е эшерихиозы
Биовар 2 – патогенные
д и а р е е г е н н ы е эшерихии
вызывают кишечные эшерихиозы
15.
Биовар 1 – эшерихии нормальной микрофлорыкишечника играют важную роль в
жизнедеятельности человеческого организма:
обеспечивают колонизационную
резистентность
участвуют в синтезе витаминов Е, В, К,
фолиевой кислоты
обладают антагонизмом против патогенных
бактерий
регулируют газовый состав кишечника
выполняют иммуногенную функцию
участвуют в инактивации токсических веществ
(детоксикационная функция)
санитарно-показательные микроорганизмы,
свидетельствующие о фекальном загрязнении
объектов окружающей среды
16. Биовар 2: Диареегенные эшерихии
Энтеропатогенные кишечныепалочки (ЭПКП) – вызывают
колиэнтерит у детей
Передаются контактно-бытовым путем
Поражают тонкий кишечник, вызывая
«секреторную диарею»
Типичный представитель E.coli О111, О55,
О26
17. Энтеропатогенные кишечные палочки (ЭПКП)
Восприимчивость детей к ЭПКП обусловленаследующими причинами:
• не сформирован иммунный ответ; медленный
запуск адаптивного иммунного ответа (IgG и IgA);
• нейтральное или близкое к нему значение рН
желудочного сока;
• не сформирована нормальная микрофлора,
обладающая антагонизмом к патогенным
бактериям;
• применение сухих молочных смесей, которые часто
контаминируются в процессе разведения их водой
(если применять некипяченую воду, делать это в
неподходящих условиях, и т.д.).
18. Патогенез поражений, вызываемых ЭПКП
Тип взаимодействия с эпителием:размножение на поверхности энтероцитов и
ограниченное поражение микроворсинок
Факторы вирулентности:
Белок наружной мембраны (интимин)
Пили IV типа (адгезия и колонизация)
ТТСС (инвазия)
19. Биовар 2: Диареегенные эшерихии
Энтеротоксигенные кишечныепалочки (ЭТКП) –вызывают
холероподобный гастроэнтерит («диарея
путешественников»)
Поражают тонкий кишечник, вызывая
«секреторную диарею»
Типичный представитель E.coli О78:Н11,
О148:Н28
20. Патогенез поражений, вызываемых ЭТКП
Тип взаимодействия с эпителием: простоеприкрепление и колонизация без
повреждения эпителия
Нарушение водно-солевого обмена
Факторы вирулентности:
пили IV типа (адгезия и колонизация)
термолабильный (LT) и
термостабильный (ST) энтеротоксины
21. Биовар 2: Диареегенные эшерихии
Энтероинвазивные кишечные палочки(ЭИКП) – поражают толстый кишечник
вызывают «инвазивную диарею» как при
дизентерии
Типичный представитель E.coli О124, О128
22. Патогенез поражений, вызываемых ЭИКП
Тип взаимодействия с эпителием:инвазия с размножением в колоноцитах
Факторы вирулентности:
Инвазивные белки наружной мембраны
Шигаподобные токсины
23. Биовар 2: Диареегенные эшерихии
Энтерогеморрагические кишечные палочки(ЭГКП) - поражают тонкий и проксимальные
отделы толстого кишечника
Вызывают «инвазивную диарею» с
геморрагическим синдромом, острой почечной
недостаточностью, иногда-тромбоцитопенической
пурпурой
Типичный представитель E.coli O157:Н7, О104:Н4
24. Патогенез поражений, вызываемых ЭГКП
Тип взаимодействия с эпителием:размножение на поверхности колоноцитов и
разрушение микроворсинок
Поражаются слепая, восходящая и
поперечная ободочная кишки
Факторы вирулентности:
Белок наружной мембраны (интимин)
Шигаподобные токсины (STEC)
Веротоксин (VTEC)
Гемолизин
25. Биовар 2: Диареегенные эшерихии
Энтероаггрегативные кишечныепалочки (ЭАКП) –поражают
преимущественно толстый кишечник
Вызывают персистирующую диарею у детей
в развивающихся странах и затяжную
диарею у взрослых в экономически
развитых государствах
Факторы патогенности - белки-адгезины,
белок дисперзин (образование биопленки),
термостабильный энтеротоксин, муциназа
26. Резистентность эшерихий
Малоустойчивы вокружающей среде
Являются санитарнопоказательными
бактериями для оценки
санитарного благополучия
объектов внешней среды –
воды и почвы
Их обнаружение в этих
объектах свидетельствует
о свежем (недавнем)
фекальном загрязнении
27. Особенности эпидемиологии кишечных эшерихиозов
Источник инфекции –человек (больной или бактерионоситель),
при ЭГКП –
сельскохозяйственные животные, растения
Механизм заражения – фекально-оральный
Пути передачи инфекции –
контактно-бытовой, водный, пищевой
28. Клиника и иммунитет
Клиника определяется серогруппой ифакторами вирулентности возбудителя
Иммунитет после выздоровления не
формируется
Важное значение имеет наличие
местного иммунитета и антагонизм
нормальной микрофлоры
29. Микробиологическая диагностика кишечных эшерихиозов
Материал для исследования:Фекалии, редко – рвотные массы
Метод исследования:
бактериологический
30. Схема бактериологической диагностики
31. Лечение кишечных эшерихиозов
Антибиотики (при тяжелом течении ималеньким детям)
Пробиотики (колибактерин,
бифидумбактерин, лактобактерин и
др.)
32. Профилактика кишечных эшерихиозов
Специфическая профилактика:не разработана
Неспецифическая профилактика:
33. сальмонеллы
34. ТАКСОНОМИЧЕСКОЕ ПОЛОЖЕНИЕ САЛЬМОНЕЛЛ
Семейство – EnterobacteriaceaeРод Salmonella
Виды: S. bongori (21 серовар – встречаются
у холоднокровных животных) и
S.enterica (возбудители болезней человека и
теплокровных животных) – 6 подвидов, а
они – на серовары. Подвид enterica
включает серовары: S. Typhi
S. Paratyphi A
S. Paratyphi B
S. Typhimurium
S. Enteritidis и др.
35. Сэлмон Дэниел (1850-1914)
Американскийветеринарный врач
Открыл возбудитель
«холеры свиней»
(1885)
Род Salmonella
получил его имя в
1933 г.
36. Морфологические и тинкториальные свойства
Мелкие грамотрицательныепалочки с закругленными концами
Спор и капсул не образуют
Могут иметь микрокапсулу
Подвижны (перитрихи)
37. Культуральные свойства сальмонелл
Факультативные анаэробыХорошо растут на простых
питательных средах
Среда обогащения – желчный
бульон
Условия культивирования: рН 7,2 –
7,4, оптимальная температура 37°С
38. Культуральные свойства сальмонелл
На лактозосодержащих средах Эндо,Левина, Плоскирева образуют
бесцветные колонии
На висмут-сульфитном агаре –
колонии черного цвета
39. Биохимические свойства сальмонелл
Высокая биохимическаяактивность высокая:
• Среда Клиглера
Глюкоза «+»
• Лактоза «-»
• Индол «-»
• Н2S «+»
• Утилизация цитрата «+»
• Лизиндекарбоксилаза «+»
40. Антигенные свойства сальмонелл
Имеют О-, Н-, К-антигеныS. Typhi имеет Vi-антиген
(разновидность К-антигена, является
рецептором для бактериофага)
Классификация по Кауфману-Уайту:
По О-антигену разделены на
серогруппы (А,В, C, D, E)
По Н-антигену – на серовары,
соответствующие названию вида
41. Факторы вирулентности сальмонелл
АдгезиныИнвазины (кодируются
островками патогенности 1)
TTSS (рус.= ТТСС)
Ингибиторы
образования
фаголизосомы
(кодируются островками
патогенности 2)
Эндотоксин
Энтеротоксин
(экзотоксин)-только у
возбудителей сальмонеллеза
42. Секреторная система 3 типа (TTSS)
TTSS ( англ. the Third TypeSecretory System) –
секреторная система,
осуществляющая доставку
факторов патогенности
бактерий в цитозоль
зараженной клетки
Изменяет цитоскелет клетки
Может активировать
фагоцитоз
непрофессиональных
фагоцитов
Вызывает апоптоз клеток
43. Резистентность сальмонелл
Относительно малоустойчивыЧувствительны к дезинфектантам,
нагреванию и УФ
Устойчивы к низким температурам
В окружающей среде могут переходить
в некультивируемую форму
44. ВОЗБУДИТЕЛИ БРЮШНОГО ТИФА И ПАРАТИФОВ
Брюшной тиф и паратифы А и В –острыегенерализованные инфекционные
заболевания человека с циклическим
течением, которые характеризуются
лихорадкой, поражением лимфоидных
органов тонкого кишечника и
интоксикацией
Возбудители относятся к Salmonella enterica,
подвид enterica, сероварианты:
S. Typhi (возбудитель брюшного тифа),
S. Paratyphi A (возбудитель паратифа А),
S. Paratyphi B (возбудитель паратифа В)
45. ОСОБЕННОСТИ ЭПИДЕМИОЛОГИИ брюшного тифа и паратифов
Источник инфекции – человек(больной или бактерионоситель).
Паратиф В может передаваться от
животных
Механизм заражения – фекальнооральный
Пути передачи инфекции – водный
(ведущий), пищевой и контактнобытовой
46. ПАТОГЕНЕЗ брюшного тифа и паратифов
«Входные ворота» инфекции – рот, ЖКТАдгезия в тонком кишечнике
Тип взаимодействия с эпителием –
трансцитоз без повреждения
Размножение в лимфоидных органах
тонкого кишечника, сенсибилизация
Захват макрофагами, размножение
Бактериемия
Фиксация в органах РЭС (печень, почки,
селезенка, красный костный мозг и др.)
Выделение сальмонелл с желчью в просвет
кишечника (возможна перфорация)
47. КЛИНИКА брюшного тифа и паратифов
Инкубационный период – 7-14 днейОстрое начало
Лихорадка (40°С), озноб
Бред, галлюцинации
Розеолезная сыпь
Циклическое течение
Продолжительность 3-4 недели
48. КЛИНИКА брюшного тифа и паратифов
49. ИММУНИТЕТ
СтойкийКлеточный иммунитет
Антитела непротективные, т.е. не
защищают от повторного заболевания, а
являются «свидетелями» инфекционного
процесса
Динамика образования антител:
О-антитела -острый период;
Н-антитела –реконвалесценция;
Vi-антитела - бактерионосительство
50.
МИКРОБИОЛОГИЧЕСКАЯДИАГНОСТИКА
БРЮШНОГО ТИФА И
ПАРАТИФОВ
51. Микробиологическая диагностика брюшного тифа и паратифов определяется патогенезом заболевания
Материал для исследования:1 неделя – кровь, 2-3 неделя – моча,
фекалии, желчь, пунктат костного мозга
Методы диагностики:
РИФ, ИФА, ПЦР для экспресс-диагностики
Бактериологический
Серологический
52. ЛЕЧЕНИЕ брюшного тифа и паратифов
антибиотикиэффективны ампициллин,
левомицетин, фторхинолоны
53. ПРОФИЛАКТИКА брюшного тифа и паратифов
Специфическая профилактика:Брюшнотифозный бактериофаг – для
экстренной профилактики
Вакцинация по эпидемическим
показаниям:
Убитая спиртовая вакцина
Химическая вакцина, обогащенная Viантигеном (Vi-полисахаридная вакцина )
Живая аттенуированная пероральная
вакцина Ty 21
54. САЛЬМОНЕЛЛЕЗ
Сальмонеллез – острая кишечнаяинфекция человека или животных,
которая характеризуется
преимущественным поражением ЖКТ
и интоксикацией, реже –
тифоподобным течением или
септикопиемией
Возбудители – Salmonella enterica,
подвид enterica, сероварианты:
S.Typhimurium, S.Enteritidis, S.Newport и др.
55. Особенности эпидемиологии сальмонеллезов
Сальмонеллезы – зооантропонозныеинфекции
Источник инфекции – животные, птицы
Механизм заражения – фекально-оральный
Пути передачи инфекции –пищевой
(основной); возможны водный и контактнобытовой
Внутрибольничный сальмонеллез
56. Патогенез сальмонеллеза
«Входные ворота» инфекции – рот, ЖКТАдгезия в тонком кишечнике
Тип взаимодействия с эпителием –
трансцитоз без повреждения
Обычно локальный процесс
Энтеротоксин активирует
аденилатциклазу, что ведет к
«секреторной диарее»
Эндотоксин активирует арахидоновую
кислоту, а затем – аденилатциклазу, что
усиливает диарею
57. Клиника сальмонеллеза
Инкубационный период – отнескольких часов до 2-3 дней
Острое начало
Гастроэнтерит
Интоксикация
Обезвоживание
58. Иммунитет при сальмонеллезе
НепродолжительныйВидоспецифический
59. Микробиологическая диагностика сальмонеллеза
Материал для исследования:Рвотные массы, промывные воды
желудка, фекалии, пищевые продукты
Метод исследования:
Бактериологический
Серологический
(при хроническом течении)
60. Лечение и профилактика сальмонеллеза
Лечение:Антибиотики (в тяжелых случаях)
Против диареи эффективны препараты кальция,
которые снижают активность аденилатциклазы
Регидратация
Специфическая профилактика:
для людей не разработана
61. ЙЕРСИНИИ – возбудители кишечного иерсиниоза и псевдотуберкулеза
62. Александр Йерсѐн (1863-1943)
Французскийбактериолог
Открыл возбудитель
чумы (Y.pestis) в
1894 г. во время
эпидемии в Гонконге
Род Yersinia носит
его имя с 1944 г.
63. Таксономическое положение и классификация йерсиний
Семейство –Enterobacteriaceae
Род Yersinia
Виды:
Y. enterocolitica (вызывает
кишечный иерсиниоз)
Y. pseudotuberculosis (возбудитель
псевдотуберкулеза)
64. Морфологические и тинкториальные свойства
Мелкие грамотрицательные палочкис закругленными концами
Окрашиваются биполярно
Спор не образуют
Могут иметь капсулу
Подвижны при температуре +18+20°С
65. Культуральные свойства
Факультативные анаэробыПсихрофилы - оптимальная
температура +22-28°С,
размножаются при + 4°С
Хорошо растут на простых
питательных средах
На среде Эндо образуют
бесцветные или бледнорозовые колонии
На жидкой среде образуют
хлопьевидный осадок без
помутнения среды
66. Биохимические свойства
Высокая биохимическая активностьДифференцируют по способности:
расщеплять мочевину, сахарозу,
рамнозу
образовывать индол и
ацетоин (в реакции Фогес-Проскауэра)
Y.enterocolitica подразделяют на
хемовары по биохимическим
свойствам
67. Антигенные свойства
Имеют О-антиген, некоторыештаммы -Н- и К-антигены
Свежевыделенные штаммы
Y.pseudotuberculosis имеют V и Wантигены (сходны с Y.pestis)
По антигенным свойствам
разделены на серовары
В патологии человека наиболее
важны О3 и О9 серовары
Y.enterocolitica и
О1 серовар Y.pseudotuberculosis
68. Факторы вирулентности
Факторы адгезии (белки наружноймембраны – Yad A протеин, пили)
Инвазивные белки
ТТСС
Нейраминидаза
Факторы защиты от фагоцитоза
(«откладывают» активацию макрофагов,
защищают от «кислородного взрыва», вызывают
апоптоз)
Эндотоксин
Цитотоксин
Энтеротоксин
Белки теплового шока и др.
69.
Некоторые факторывирулентности
термозависимы, т.е.
Вирулентность
иерсиний повышается
при понижении
температуры
Сапрофиты
окружающей среды!!!
после пребывания
Стационарная фаза при
низкой температуре –
от 2 до 6 месяцев
Т.о., иерсинии
«двуличны»:
на холоде
Паразиты
при t +25C и выше
70. Резистентность
Малоустойчивы вокружающей среде
Чувствительны к
нагреванию, УФ лучам и
дезинфектантам
Долго сохраняются в
замороженном состоянии
Вступают в симбиоз с
инфузориями
Поступают в растения с
водой по тканевым каналам
71.
Кишечный иерсиниоз –инфекционная болезнь,
характеризующаяся первичным
поражением ЖКТ, тенденцией к
генерализации с вовлечением
различных органов и систем
72.
Псевдотуберкулез – остраяинфекционная болезнь, которая
характеризуется полиморфной
клинической картиной.
Сопровождается лихорадкой,
интоксикацией, мезентериальным
лимфаденитом, микроабсцессами во
внутренних органах, поражением печени,
суставов и часто протекает со
скарлатиноподобной сыпью (экзантемой)
73. Особенности эпидемиологии
Кишечный иерсиниоз ипсевдотуберкулез - сапронозы
Источник инфекции и резервуар
возбудителя в природе –
различные млекопитающие, грызуны,
почва, вода, растения
Механизм заражения –
фекально-оральный
Пути передачи инфекции –
пищевой, водный
74. Патогенез иерсиниозов
«Входные ворота» инфекции – рот, ЖКТАдгезия в тонком кишечнике
Тип взаимодействия с эпителием –
трансцитоз с повреждением
Преимущественно поражают дистальные
отделы подвздошной и слепой кишки –
илеоцекальный угол
Транспортируются макрофагами в
мезентериальные лимфоузлы
(мезентериальный лимфаденит)
Возможна генерализация (сепсис)
75. ПСЕВДОТУБЕРКУЛЕЗ (дальневосточная скарлатиноподобная лихорадка)
76. Клиника иерсиниозов
Клинические формы иерсиниозов:гастроэнтероколитическая
аппендикулярная
ангинозная
септическая
Осложнения: системный васкулит,
реактивный артрит, миокардит,
гломерулонефрит, узелковая
эритема, сепсис и др.
77. Иммунитет
Иммунитет после выздоровления неформируется
78. Микробиологическая диагностика иерсиниозов
Материал для исследования:фекалии, кровь, моча, операционный
материал, суставная жидкость,
секционный материал, пищевые
продукты
79.
Методы диагностики:ПЦР
Бактериоскопический
(ориентировочный)
Бактериологический
(обязательно «холодовое
обогащение»)
Биологический (редко)
Серологический
80. Лечение и профилактика иерсиниозов
Лечение:Антибиотики
Специфическая профилактика:
не разработана
Неспецифическая профилактика:
Дератизация
Термическая обработка пищи
Санитарно-гигиенические мероприятия
81. Шигеллы – возбудители бактериальной дизентерии (шигеллеза)
82. Таксономическое положение и классификация
Семейство – EnterobacteriaceaeРод Shigella
Виды:
S.dysenteriae (группа А)дизентерия Григорьева-Шига
S.flexneri (группа В) –
дизентерия Флекснера
S.boydii (группа С)- дизентерия Бойда
S.sonnei (группа D) –
дизентерия Зонне
83. Шига Киеси (1870-1957)
Японскийбактериолог
Открыл возбудителя
дизентерии (1897) во
время эпидемии в
Японии
Род получил его имя
в 1919 г.
84. Флекснер Саймон (1863-1946)
Американскийбактериолог
Выделил и описал
вид шигелл(1900),
получивший позднее
название Shigella
flexneri
85. Морфологические и тинкториальные свойства
Мелкие грамотрицательные палочкис закругленными концами
Спор и капсул не образуют
Могут иметь микрокапсулу
Неподвижны
86. Культуральные свойства шигелл
Факультативные анаэробыХорошо растут на простых питательных
средах
На дифференциально-диагностических
средах с лактозой образуют бесцветные
колонии
Условия культивирования: рН питательной
среды 7,2 – 7,4; температура 37°С
87. Биохимические свойства шигелл
Биохимическая активностьотносительно низкая
Глюкоза «+»
Лактоза «-» , кроме
S.sonnei (лак «+», 72ч.)
Н2S «–»
Группа А - маннит«-»,
остальные – маннит«+»
88. Биохимические свойства шигелл
1.2.
3.
4.
5.
6.
Верхний ряд –
S.sonnei
Нижний ряд –
S.Typhimurium
глюкоза
маннит
лактоза
сахароза
дульцит
мочевина
89. Антигенные свойства шигелл
Имеют О- и К-антигеныРазделены на серовары
S.dysenteriae (группа А)12 сероваров
S.flexneri (группа В) –
8 сероваров
S.boydii (группа С)18 сероваров
S.sonnei (группа D) -1 серовар
90. Факторы вирулентности шигелл
Факторы адгезии(белки наружной
мембраны и фимбрии)
ТТСС
Инвазивные белки
(ipa-белки)
Белковые
экзотоксины – токсин
Шига (ST) и Шигаподобный токсин (SLT)
Белки межклеточного
распространения
Эндотоксин
91. Резистентность шигелл
НизкаяЧувствительны к дезинфектантам и УФ
Погибают в кислой среде и под действием
бактериофага, поэтому:
Посев у постели больного
Доставка материала (фекалий) в
транспортной среде с консервантом
92. Особенности эпидемиологии шигеллезов
Источник инфекции –человек (больной или бактерионоситель)
Механизм заражения –
фекально-оральный
93. Особенности эпидемиологии шигеллезов
Пути передачи инфекции –дизентерия Григорьева-Шига –
контактно-бытовой;
дизентерия Флекснера - водный;
дизентерия Бойда - водный и пищевой;
дизентерия Зонне – пищевой (алиментарный)
94. Патогенез шигеллеза
«Входные ворота» инфекции – рот, ЖКТАдгезия в толстом кишечнике
Тип взаимодействия с эпителием –
инвазия с размножением
Процесс локальный (колит)
Выделение экзотоксина, обладающего
цитотоксическим действием
Гибель колоноцитов с развитием эрозий и язв
95. Клиника шигеллеза
Бактериальная дизентерия (шигеллез)– острое или реже хроническое
инфекционное заболевание человека с
язвенным поражением толстого кишечника
Инкубационный период – 2-5 дней
Острое начало
Лихорадка
Диарея, тенезмы
Стул с примесью крови, слизи и гноя
Иммунитет непродолжительный
96. Микробиологическая диагностика
Материал для исследования:фекалии; пищевые продукты,
объекты внешней среды
Методы исследования:
ПЦР, ИФА, латекс-агглютинация
Бактериологический
Серологический (РНГА для
ретроспективной диагностики и при
хронической дизентерии)
97. Лечение шигеллеза
антибиотики (при тяжеломтечении)
NB: шигеллы устойчивы к
тетрациклину и ампициллину
эффективны фуразолидон и
интестопан
пробиотики (колибактерин,
бифидумбактерин, бификол
и др.)
98. ПРОБИОТИКИ
99. Профилактика шигеллезов
Специфическая профилактика:Дизентерийный бактериофаг – для
экстренной профилактики
Вакцинация по эпидемическим показаниям
и группам риска:
Живые аттенурованные пероральные
вакцины
Конъюгированные О-полисахариднобелковые вакцины и
Липополисахаридные вакцины
(«Шигеллвак» против дизентерии Зонне)

medicine
medicine








